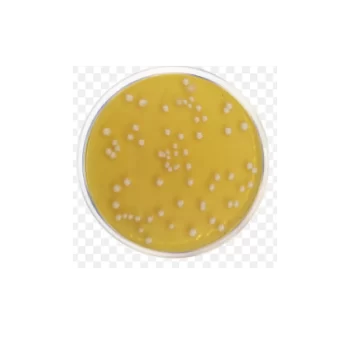

Showing 181–189 of 214 results
Plate Count Agar (Dehydrated) / Agar para recuento en placa (deshidratado)
S/ 0.00
[SKU: CM0325B]
Determine los recuentos en placa de microorganismos en alimentos, muestras de lácteos, aguas residuales y otros materiales de importancia sanitaria con el agar para recuento en placas Thermo Scientific™ Oxoid™ (deshidratado).
Potato Dextrose Agar (EP/USP/JP/BP) (Dehydrated) / Agar Papa Dextrosa (EP/USP/JP/BP) (Deshidratado)
S/ 0.00
[SKU: CM0139B]
Aísle y enumere levaduras y mohos de productos lácteos y alimenticios 1 y prepare Aspergillus niger para las pruebas de límite microbiano armonizadas de la farmacopea internacional 2,3,4 con agar dextrosa de patata (deshidratado) Thermo Scientific™ Oxoid™.
Pseudomonas Agar Base (Dehydrated) / Base de agar Pseudomonas (deshidratada)
S/ 0.00
[SKU: CM0559B]
Aísle selectivamente especies de Pseudomonas de una variedad de muestras con la base de agar para Pseudomonas (deshidratada) Thermo Scientific™ Oxoid™.
Raka-Ray Agar Base (Dehydrated) / Base de agar Raka-Ray (deshidratada)
S/ 0.00
[SKU: CM0777B]
Aísle las bacterias del ácido láctico en la cerveza y los procesos de elaboración de cerveza con la base de agar Raka-Ray Thermo Scientific™ Oxoid™ (deshidratada).
Rappaport-Vassiliadis Enrichment Broth (Dehydrated) / Caldo de enriquecimiento Rappaport-Vassiliadis (deshidratado)
S/ 0.00
[SKU: CM0669B]
Enriquece selectivamente Salmonella spp. a partir de muestras de alimentos y ambientales con caldo de enriquecimiento Thermo Scientific™ Oxoid™ Rappaport-Vassiliadis (deshidratado).
Rappaport-Vassiliadis Soya Peptone Broth (Dehydrated) / Caldo de peptona de soja Rappaport-Vassiliadis (deshidratado)
S/ 0.00
[SKU: CM0866B]
Enriquece selectivamente Salmonella spp. a partir de muestras alimentarias y medioambientales con caldo de peptona de soja Thermo Scientific™ Oxoid™ Rappaport-Vassiliadis (deshidratado).
Rifampcin Antimicrobial Susceptibility discs / Discos de susceptibilidad antimicrobiana a rifampcina
S/ 0.00
[SKU: CT0104B]
Determine manualmente la susceptibilidad a los antibióticos de los microorganismos utilizando métodos de prueba de susceptibilidad a los antimicrobianos (AST) junto con discos de susceptibilidad a los antimicrobianos Thermo Scientific™ Oxoid™ rifampcina confiables y fáciles de usar.
Sabouraud Liquid Medium EP/USP/JP/BP (Dehydrated) / Medio Líquido Sabouraud EP/USP/JP/BP (Deshidratado)
S/ 0.00
[SKU: CM0147B]
Realice con confianza pruebas de esterilidad o determine la actividad fungistática de productos farmacéuticos con el medio líquido Thermo Scientific™ Oxoid™ Sabouraud (deshidratado).
Signal blood culture system / Sistema de hemocultivo Signal
S/ 0.00
[SKU: BC0100M]
Detecte el crecimiento de organismos aeróbicos, anaeróbicos y microaerófilos a partir de muestras de sangre con el sistema de hemocultivo Thermo Scientific™ Oxoid™ Signal™.